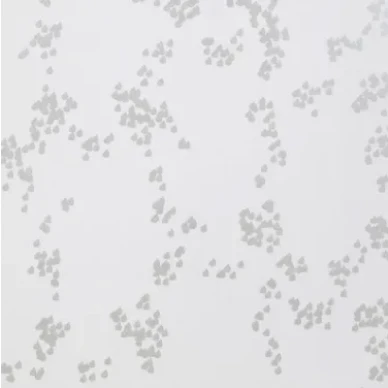

Falling Flowers tapet
Mimou
Falling Flowers är en blommig tapet med blanka och matta färger.
ENDAST 1 TAPET KVAR AV DENNA BATCH!
Produktkod: WP1045
Inte tillgänglig för tillfället.
Lägsta priset under de senaste 30 dagarna
64,00 €
Nuvarande pris
65,60 €
Specifikationer
Taggar:
Stil:
Blommor
Material:
Non woven
Rullängd:
10,05 m
Rullbredd:
53 cm
Mönsterupprepning:
53 cm
Skötselråd:
tvättbar
Miljö & certifiering:
OEKO-TEX Standard 100,
FSC-certifierad
Ljushärdighet:
God ljushärdighet 5-6
Brandklass:
brandklass B-s1, d0
Tillverkningsland:
Sverige

Psst. Alvar - din AI-assistent gjorde dessa förslag till dig!
Psst. Alvar - din AI-assistent gjorde dessa förslag till dig!








